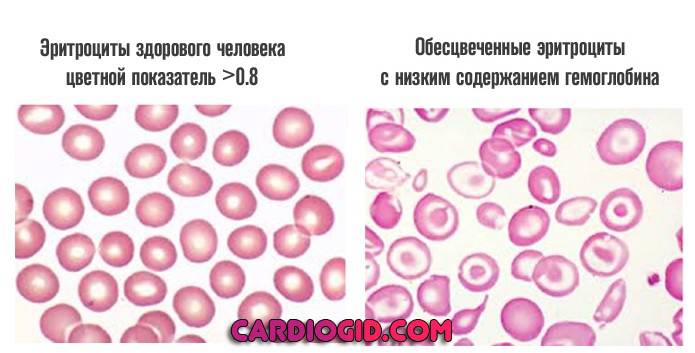
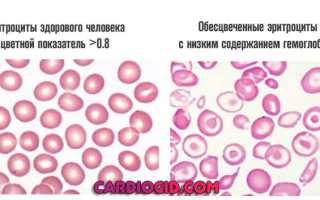

Показания ниже нормы
Низкое содержание гемоглобина в эритроцитах указывает на гипохромную анемию. Наиболее распространенной формой является анемия, вызванная дефицитом железа, что означает, что организм не усваивает его в достаточном количестве.
Снижение взаимосвязи между железом и гемоглобином отражается в анализах, показывающих падение уровня гемоглобина ниже нормы. Недостаток эритроцитов может свидетельствовать о:
- воспалительных процессах;
- нарушениях обмена железа (железодефицитная анемия);
- гиповитаминозе (недостатке витаминов);
- длительной интоксикации свинцом.
Снижение уровня MCH влияет на биохимические процессы в организме и ухудшает общее состояние. Это может проявляться в постоянной слабости, усталости, бледности, сухости кожи и ломкости волос. Другие симптомы включают онемение в конечностях, трещины в уголках рта, аритмию и проблемы с ногтями.
* * *
Улучшить самочувствие и нормализовать показатели крови можно без медикаментов. Для этого следует пересмотреть режим дня, обеспечить полноценный сон и питание, включая больше продуктов, богатых железом. Полезно принимать витаминные комплексы, особенно витамин B12. Также важно следовать назначенной врачом терапии, повторно сдавать анализы и не забывать об отдыхе.
Не стоит паниковать, если результаты анализов не соответствуют норме. Обсудите с лечащим врачом свой рацион, режим дня и препараты, которые вы принимаете. Повторная сдача анализа поможет подтвердить результаты.
Не исключайте возможность ошибки лаборанта, что, к сожалению, бывает в медицинской практике. Повышенные показатели анализа не всегда означают серьезные проблемы. Квалифицированный специалист сможет выявить ошибку на основе визуального осмотра и других исследований. При необходимости можно повторно сдать анализ на уровень MCH.
Повышенный или пониженный MCH в анализе крови — что значит?
Информация о показателях MCH в анализах крови имеет важное значение при постановке диагноза, так как данные о эритроцитарных индексах отражают ключевые физиологические процессы в организме.
MCH (Mean Corpuscular Hemoglobin) — это один из эритроцитарных индексов, используемых для диагностики патологий. Тест MCH входит в общий анализ крови и проводится в поликлиниках.
Эритроцитарные индексы характеризуют состояние эритроцитов — красных кровяных клеток, которые обеспечивают доставку кислорода к тканям организма.
Гемоглобин, белок красного цвета, является важной частью эритроцитов и отвечает за их окрас. Он содержит атомы железа, связывающие кислород. Таким образом, уровень кислорода в организме зависит от количества эритроцитов и массы гемоглобина в крови.
Существуют нормы для количественных и качественных показателей эритроцитов и гемоглобина. Повышенное количество эритроцитов может привести к повышению плотности крови и тромбозу. Пониженное количество указывает на кислородное голодание, что также может иметь серьезные последствия.
Аналогичная ситуация наблюдается с гемоглобином: его повышение или понижение считается патологическим и требует дополнительных исследований.
Средняя масса гемоглобина в эритроцитах определяется с помощью общего анализа крови, в частности, исследования MCH. Расшифровка анализа показывает среднее содержание гемоглобина в одном эритроците и указывает на качество усвоения железа в организме.
Индекс MCH вычисляется по двум параметрам: показателю гемоглобина (г/л) и количеству эритроцитов. Формула расчета: показатель гемоглобина делится на количество эритроцитов и умножается на 10^12. Индекс среднего содержания гемоглобина в эритроците измеряется в пикограммах (пг).
Методы коррекции показателя
Чтобы нормализовать показатель, необходимо сначала провести дополнительные исследования для выявления его причин, а затем разработать соответствующий терапевтический подход.
Если изменение коэффициента связано с заболеванием, внимание следует сосредоточить на лечении основной патологии. Если серьезные болезни не обнаружены, уровень МСНС можно скорректировать с помощью определенных препаратов и питания.
Терапия при снижении МСНС
При пониженном уровне гемоглобина назначаются препараты, повышающие его концентрацию. Рекомендуется также прием фолиевой кислоты и минеральных комплексов. Важно включить в терапию витамины группы В.
Если у ребенка диагностирована нехватка гемоглобина, с ранних лет могут назначаться препараты, такие как Феррум Лек, Актиферрин и Мальтофер. С 3 лет можно использовать Ферроплекс, Тардиферон и Тотема. Эти лекарства основаны на природных компонентах и подходят для детей. Взрослым назначаются те же препараты, но в больших дозах.
Средний курс терапии длится 1-3 месяца. Продолжительность лечения и частота приема зависят от состояния пациента и индивидуальных особенностей. Если не удается подобрать пероральный препарат из-за противопоказаний, пациента госпитализируют для внутривенных или внутримышечных инъекций под контролем медперсонала.
К медикаментозной терапии рекомендуется добавить продукты с высоким содержанием железа, такие как печень, красное мясо, яблоки и гречка. Также важно включить в рацион продукты с высоким содержанием фолиевой кислоты: цитрусовые, орехи, крупы, кукурузу, морковь, свеклу, капусту, тыкву, помидоры, яблоки, абрикосы и груши.
Лечение при повышении МСНС
Если при расшифровке данных ОАК выявлен повышенный уровень МСНС, первым шагом для его снижения назначается обильное питье и соленая пища. Мумие также может быть полезным. Из рациона следует исключить все красные фрукты, красное мясо, печень и крупы, заменив их бобовыми, куриным мясом, кисломолочными продуктами, морепродуктами и овощами.
Пациенту необходимо отказаться от алкоголя, жирной и жареной пищи. Запрещено принимать поливитамины с витаминами группы В и фолиевой кислотой. При высоком уровне МСНС назначаются препараты Кардиомагнил, Трентал и Курантил.
Среди немедикаментозных методов широко используется гирудотерапия. Пиявки не только высасывают кровь, но и вводят в нее вещества, препятствующие сгущению. Несмотря на их непривлекательный вид, они являются эффективным средством лечения.
Отклонения MCHC от нормы
Величина MCHC — одна из стабильных характеристик эритроцитов. Этот индекс отклоняется от нормы при серьезных нарушениях крови.
Определение MCHC обязательно при плановом обследовании, так как позволяет своевременно выявить анемию. Анализ назначается при диагностике состояний, связанных с:
- беспричинной слабостью и снижением работоспособности;
- прогрессирующим воспалением инфекционного или неинфекционного характера;
- значительной кровопотерей.
Если подготовка к сдаче анализа была выполнена правильно и в лаборатории не допущено ошибок, показатель MCHC будет в пределах нормы или снизится.
Повышение индекса МСНС
Повышение MCHC в анализе крови может быть связано с лабораторной ошибкой или заболеванием, таким как сфероцитоз.
Сфероцитоз — наследственное заболевание, вызванное нарушением эластичности клеточных мембран красных кровяных телец. Это врожденная патология, и если ни у кого из членов семьи не было диагностировано это заболевание, то оно не проявится во взрослом возрасте.
Также повышение MCHC может наблюдаться у людей, проживающих на больших высотах. В таких условиях организм компенсирует нехватку кислорода в разреженном воздухе увеличением синтеза гемоглобина.
Если в анализе крови повышена MCHC, это не обязательно указывает на заболевание. Скорее всего, причина отклонения — ошибка в расчете гемоглобина и гематокрита в лаборатории.
Повышение этого эритроцитарного индекса означает, что эритроциты насыщены гемоглобином. При значительном превышении нормы может начаться кристаллизация гемоглобина внутри красных кровяных клеток.
Кристаллизация повреждает клетки и приводит к гемолизу — разрушению эритроцитов.
При высоких показателях MCHC анализ следует пересдать. Если повторный результат также превышает норму, пациенту рекомендуется дальнейшее обследование для исключения гиперхромной анемии, эритремии или серьезных нарушений водно-солевого баланса.
Понижение МСНС
Снижение MCHC может быть вызвано железодефицитной анемией, отравлением свинцом или аутоиммунными нарушениями.
Пониженные значения МСНС в крови могут указывать на В9- или В12-дефицитную анемию, особенно при наличии гигантских эритроцитов.
У женщин уровень МСНС может снижаться во время менструации, особенно при значительной кровопотере.
Когда ждать результатов
Среднее время ожидания результатов составляет от 30 минут до двух часов. Этот срок может увеличиваться в зависимости от технического обеспечения и загруженности лаборатории.
В бланке с результатами указываются следующие параметры:
- количество лейкоцитов;
- уровень MCHC в крови;
- скорость оседания эритроцитов (СОЭ).
При развернутом исследовании список параметров будет другим. Если анализ выполняется в экстренном порядке (CITO), результаты готовы за 10-30 минут. Обычно их направляют сразу ведущему специалисту для расшифровки.
Причины снижения и лечение
Существует множество факторов, вызывающих падение показателя:
Талассемия и прочие наследственные отклонения
При этом расстройстве вырабатывается недостаточное количество гемоглобина. Патология имеет генетическое происхождение и передается по рецессивному типу. Это означает, что заболевание проявляется, если оба родителя являются носителями дефектного гена и передают его потомству.
Существуют и другие расстройства, помимо талассемии.
Что касается лечения, специальной терапии не существует. Необходима симптоматическая коррекция. Из-за разнообразия проявлений заболевания универсальные рекомендации дать невозможно. Врачи ориентируются на конкретную клиническую ситуацию, так как синтез гемоглобина нарушается на одной из нескольких фаз.
Дефицит витамина B6
Принципиально это не отличается от недостатка витамина B12 или фолиевой кислоты. Разница заключается в курсе лечения. Вещество вводят извне, чтобы скорректировать дефицит и восстановить кроветворение.
Патологии печени
Различные заболевания печени, такие как гепатиты, воспалительные процессы и цирроз, приводят к отмиранию клеток органа. Эти патологии вызывают недостаточность и дисфункцию печени, что приводит к нарушениям в системе кроветворения.
Костный мозг начинает функционировать с перебоями, синтез гемоглобина ухудшается, уровень MCHC в крови снижается, возникают коагулопатии. Чем более запущено расстройство, тем серьезнее последствия.
Для лечения необходимо восстановить работу печени и защитить ее от вредных факторов, чтобы предотвратить прогрессирование болезни. Для этого применяют гепатопротекторы, такие как Эссенциале и Карсил, которые принимают курсами на протяжении длительного времени.
Рекомендуется регулярное наблюдение у гастроэнтеролога. Лучше, если есть возможность обратиться к узкоспециализированному врачу — гепатологу.
Железодефицитная анемия
Еще одна разновидность заболевания связана с недостатком железа. Гемоглобин содержит атомы железа (Fe), что делает его активным и способным связывать и транспортировать газы. При нехватке этого элемента синтез гемоглобина становится невозможным.
Недостаток пигмента приводит к тому, что эритроциты слабо насыщены гемоглобином и имеют бледный цвет. При длительном патологическом процессе кроветворение меняется: вырабатывается слишком много форменных клеток, среди которых много незрелых.
Если в анализе крови повышены показатели и MCH, врач может заподозрить один из видов анемии. Однако это лишь следствие изменений в составе клеток и нарушений функции, а не причина. Часто корневые проблемы связаны с системными сбоями, такими как:
- гипотиреоз;
- лейкоцитоз;
- нарушения обмена витаминов группы В;
- накопление гепарина.
Резкие колебания уровня гемоглобина указывают на разрушение эритроцитов. Это состояние называется гиперхромией и может развиваться под воздействием различных препаратов. Для женщин опасность представляют длительные курсы оральных контрацептивов. У взрослых повышение показателя может свидетельствовать о патологиях органов в стадии обострения, таких как:
- почечная недостаточность;
- поражения печени, включая цирроз;
- лейкоз;
- новообразования.
Лейкоциты разрушаются при нехватке витаминов группы В, особенно В9 и В12. В таких случаях часто наблюдается нарушение усвоения этих элементов, что требует назначения высоких доз. Нарушения обмена веществ приводят к накоплению жира в крови, что изменяет ее состав и консистенцию, затрудняя прохождение по мелким сосудам и капиллярам. Повышенный MCH может указывать на риск образования мегабластов.
Понижение уровня MCH называется гипохромией, и основной ее причиной является недостаток железа. Организм усваивает его из пищи и не производит самостоятельно. Даже при здоровом рационе усвояемость может быть низкой, что приводит к тому, что эритроциты не могут эффективно переносить кислород. Основные причины гипохромии:
- хронические или острые воспаления;
- длительный гиповитаминоз;
- интоксикация свинцом;
- врожденная железодефицитная анемия.
Анемия может быть вызвана наследственными заболеваниями, которые нарушают формирование гемоглобина. Причины могут быть как генетическими мутациями, так и приобретенными патологиями, перешедшими в хроническую стадию. В некоторых случаях резкое падение уровня гемоглобина связано с паразитарными инфекциями или массивными кровопотерями.
На заметку!
Снижение MCH может указывать на глистную инвазию, что свидетельствует об активном размножении паразитов.
Расшифровка повышенных показателей
Результаты анализа крови представлены в заключении, но для понимания терминов необходима профессиональная расшифровка.
Патологией считаются показатели, выходящие за пределы нормы. По характеру отклонений можно определить причины и диагностировать заболевание.
Повышенный индекс MCH обычно указывает на гиперхромию — состояние эритроцитов с увеличенным содержанием гемоглобина. Однако это не всегда означает, что концентрация пигмента возросла; чаще всего причина кроется в увеличении объема эритроцитов.
Гиперхромия охватывает различные виды анемии, которая сама по себе является признаком патологии. Причины повышения гемоглобина в эритроцитах связаны с общим объемом клеток, а не с концентрацией пигмента в каждой клетке.
Индекс MCH может быть повышен по следующим причинам:
- выраженный лейкоцитоз;
- холодовые агглютинины;
- разрушение эритроцитов;
- наличие моноклональных белков в крови;
- высокая концентрация гепарина;
- повышенное содержание жиров в крови.
Гиперхромная анемия часто связана с избытком гемоглобина, который может повышаться при мегалобластной анемии, характеризующейся появлением мегалобластов. Основные причины мегалобластной анемии включают дефицит витамина B12, недостаток витамина B9, миелодиспластический синдром и влияние различных лекарств, применяемых при злокачественных опухолях, ревматических и аутоиммунных заболеваниях, эпилепсии и ВИЧ-инфекции.
Индекс MCH также может повышаться при заболеваниях печени, алкоголизме, гипотиреозе, опухолях, лейкозах и апластической анемии. Кроме того, он может быть повышен у людей, длительное время принимающих противозачаточные средства.
В некоторых случаях возможен неверный расчет при анализе крови. Поэтому, если в заключении указано, что индекс MCH повышен, это не всегда повод для беспокойства. Причины аномалии могут заключаться в ошибке расчета.
Причины повышения
Рост показателя связан с серьезными и опасными состояниями. Конкретные виновники:
Острые инфекционно-воспалительные процессы
Септические расстройства непредсказуемы, поэтому возможны различные варианты их проявления. Задача врачей — выявить источник инфекции и устранить его. Лечение аналогично ранее описанному: используются антибиотики, стимуляторы выработки интерферона или готовые антитела. Решение принимает специалист — гематолог.
Атеросклероз, нарушение переработки жиров
Расстройства обмена веществ, транспортировки и депонирования липидов.
Лечение зависит от типа нарушения. Чаще всего назначают статины для снижения уровня жиров и риска атеросклероза, а также отложения бляшек на стенках артерий. Если статины неэффективны или не подходят, применяют фибраты. Также может быть назначена никотиновая кислота. Пациентам с атеросклерозом рекомендуется диета с минимальным содержанием животного жира.
Распад эритроцитов
Разрушение под воздействием токсичного фактора, например, гемолитического стрептококка. Организм пытается компенсировать недостаток красных кровяных телец, насыщая их пигментом. При лабораторной оценке часто возникают ложные результаты.
Лечение. Необходимо устранить причину проблемы. Если это инфекция, назначают антибиотики или противовирусные препараты. При эндогенном процессе ситуация может ухудшаться, и тогда требуется переливание эритроцитарной массы. Далее действия зависят от обстоятельств.
Применение некоторых препаратов
Частая причина повышения MCH — прием антикоагулянтов, гепаринов, противовоспалительных средств, некоторых антибиотиков и гормонов. Оральные контрацептивы и глюкокортикоиды также негативно влияют на клетки.
Ситуацию можно легко исправить. Достаточно отменить препарат и назначить аналогичный по клинической эффективности.
Заболевания печени составляют самый крупный блок причин. Сюда входят все формы гепатита (воспаление инфекционного генеза), гепатоз (замещение функциональных тканей жировыми) и цирроз (отмирание клеток с утратой способности органа функционировать). Вариантов множество, и все они крайне опасны. Главная задача заключается не только в коррекции показателя, но и в лечении основного диагноза.
Длительное потребление спиртного
Содержание гемоглобина в эритроцитах повышается из-за стресса. Организм пытается быстрее вывести продукты распада этанола, а также компенсировать нарушенный кровоток и клеточное дыхание за счет активного насыщения эритроцитов.
Лечение. Достаточно отказаться от алкоголя. Однако на выраженных стадиях зависимости этого может быть недостаточно. В таких случаях потребуется курс реабилитации и назначение поддерживающей терапии для нормализации работы всех органов.
Неопластические процессы
Опухоли могут быть как злокачественными, так и доброкачественными. Концентрация пигмента увеличивается из-за усиленной работы организма — это компенсаторный механизм. Особенно это заметно на поздних стадиях рака, когда опухоль начинает распадаться. Чтобы обеспечить ткани кислородом, организм увеличивает количество гемоглобина в каждой клетке, хотя общее число красных кровяных телец может снижаться из-за кровотечений и других причин.
Лечение. Повышение MCH не корректируется, так как это бессмысленно и невозможно. Специалисты сосредотачиваются на основной проблеме — хирургическом удалении опухоли. При необходимости применяются цитостатики (химиотерапия) или облучение пораженной области. После удаления опухоли и восстановления пациента показатели вернутся в норму.